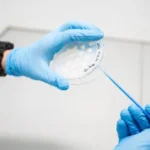

Первый пилотируемый полет на Марс: НАСА приступает к подготовке
В то время как НАСА продвигается в реализации планов по отправке астронавтов на Луну, специалисты НАСА также думают об освоении Марса человеком. Первая миссия, в ходе которой четыре человека будут отправлены туда на тридцать дней, уже находится в разработке.
После Луны — планета Марс. Это заявленная цель НАСА, которое, согласно текущим планам, стремится осуществить первый пилотируемый полет в конце 2030-х годов. Чтобы достичь этого, необходимо будет преодолеть множество технических, технологических и связанных со здоровьем астронавтов проблем.
Для начала, если все эти задачи будут решены, американское агентство хотело бы отправить первую миссию с участием четырех человек, двое из которых могли бы отправиться на поверхность.
30-дневная миссия в герметичном марсоходе
План миссии все еще находится в стадии становления и может значительно измениться в течение следующих нескольких лет. Однако на данный момент НАСА рассматривает возможность использования космического корабля, похожего на среду обитания, для доставки членов экипажа на Красную планету. Идея заключается в использовании гибридной ракетной ступени (работающей как на химической, так и на электрической тяге). Путь туда и обратно займет около 500 дней. Астронавты останутся на месте в течение тридцати дней.
Гравитация, или ее отсутствие, будет здесь проблемой. Эти астронавты прибудут после нескольких месяцев пребывания в условиях микрогравитации, поэтому им потребуется время на восстановление. Кроме того, марсианская гравитация примерно в три раза меньше земной. Одним из способов решения этой проблемы было бы проживание астронавтов в герметичном марсоходе во время их миссии. Затем они смогут совершить несколько выходов в открытый космос для исследования поверхности.
Около двадцати пяти тонн припасов и оборудования будет заранее отправлено роботизированной миссией. Эти припасы будут включать в себя предварительно заряженный энергией подъемный аппарат, который позволит астронавтам покинуть Марс и выйти на орбиту вокруг планеты. Оттуда они присоединятся к двум другим астронавтам и вернутся на Землю.
В итоге архитектура миссии весьма похожа на архитектуру лунных миссий «Аполлон».
Во вторник 17 мая агентство опубликовало основные цели этой гипотетической 30-дневной пилотируемой миссии и попросило общественность высказать свое мнение о развитии планирования. У заинтересованных лиц есть время до 3 июня. В июне будет также запланирован семинар с участием партнеров из промышленности и научных кругов США. Ряд международных организаций также могут принять участие в семинаре в июле.
Как видите, эта миссия все еще находится в зачаточном состоянии. Тем временем НАСА сосредоточено на запуске миссии Артемида-1 для подготовки к пилотируемым полетам на Луну в конце этого десятилетия. Эта работа над нашим спутником будет необходима для подготовки к полету на Марс.